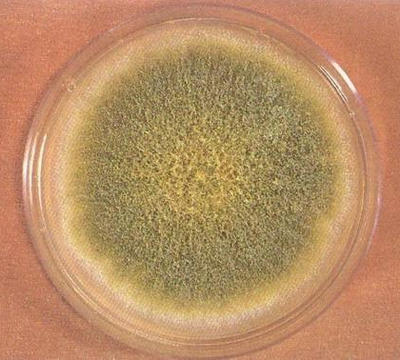
強堿可以起到殺滅黃曲霉素的作用哦

網(wǎng)站地圖|聯(lián)系我們 | 魯ICP備14031516號
魯公網(wǎng)安備 37069302000952號 版權所有:煙臺合興塑料制品有 關鍵詞:塑料砧墩 塑料菜墩 塑料菜板
塑料砧板 網(wǎng)站建設:煙臺網(wǎng)億智能建站
友情鏈接:
復合面料
橡膠發(fā)泡管
金屬制品
養(yǎng)生館加盟
廈門月子中心哪家好
重慶物流公司
中國茶文化
鄭州物業(yè)管理
石家莊保潔公司
白剛玉
石斛價格
民權網(wǎng)
濰坊搬家公司電話
實木辦公家具
隔聲墻
實木椅子
煙臺整體家裝
臥式承壓熱水鍋爐
水泥仿樹皮護欄
鶴管
電動面條機
隔離膜
奕德堂牙膏
舟山律師
產(chǎn)品有: